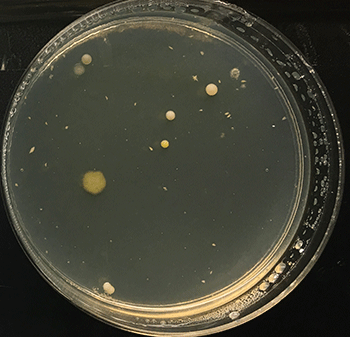
350-inline-1-5-sec-rule4.gif

The five-second rule: Microbes can’t count
Other scientists have studied the five-second rule and agree — it’s a lie
I swabbed bologna for science. Other scientists have tried testing the five-second rule with bread, watermelon and gummy candies.
Explainr
Share this:
- Share via email (Opens in new window) Email
- Click to share on Facebook (Opens in new window) Facebook
- Click to share on X (Opens in new window) X
- Click to share on Pinterest (Opens in new window) Pinterest
- Click to share on Reddit (Opens in new window) Reddit
- Share to Google Classroom (Opens in new window) Google Classroom
- Click to print (Opens in new window) Print
This article is one of a series of Experiments meant to teach students about how science is done, from generating a hypothesis to designing an experiment to analyzing the results with statistics. You can repeat the steps here and compare your results — or use this as inspiration to design your own experiment.
Everyone has dropped food on the floor. And many might think that if they pick it up quickly, microbes haven’t had time to crawl on. The latest DIY Science video tests this “five-second rule” with an experiment. Previous blog posts in this series detail how that experiment was designed and conducted. The experiment’s results showed that five seconds on the floor or not, all of the food hosted germs.
Others have tested the five-second rule, too! The general conclusion from them all is that microbes aren’t waiting to count to five. Once food has hit the floor, maybe it’s best to let it lie.
Jillian Clarke tested the five-second rule in 2003. The then-high school student was doing summer research in the lab of Hans-Peter Blaschek. He is a food scientist at the University of Illinois, Urbana-Champaign. Clarke covered smooth and rough flooring tiles with bacteria. Then she dropped gummy bears and fudge cookies on the tiles. The teen found that after five seconds, the cookies and candy had picked up bacteria. Also, more bacteria was transferred onto gummy bears when they fell onto smooth tiles than rough ones.
Adult scientists have also taken on the rule. Paul Dawson and a group of food scientists at Clemson University in South Carolina smeared Salmonella — a type of bacteria that can cause disease — onto carpet, wood and tile. The researchers then dropped bologna and bread.
The longer the bacteria had been left to dry on the floor, the fewer microbes that ended up on the food. The carpet transferred fewer germs to the bologna than did the other surfaces, the team found. And food that had been left on the surfaces longer picked up more bacteria. But picking up food before five seconds had passed didn’t keep them clean. Bologna and bread both picked up germs during that time. Dawson and his food-dropping fellows published their results October 6, 2006 in the Journal of Applied Microbiology.
Robyn Miranda and Donald Schaffner dropped food onto floors for science at Rutgers University in New Brunswick, N.J. The scientists tested strawberry gummy candy as well as watermelon, bread and buttered bread. They dropped the foods onto different surfaces contaminated with bacteria — steel, tile, wood and carpet. They let the food lie there for times ranging from five seconds to as long as five minutes.
All picked up microbes, but the winner was watermelon. That fruit became covered in bacteria no matter the surface. The researchers also showed that carpet transferred the fewest bacteria. And while longer times meant more germs, anything longer than a second was long enough for microbes to hop on board. The scientists published their results September 2, 2016 in Applied and Environmental Microbiology.
The most famous test of the five-second rule, though, comes from the television show Mythbusters. Hosts Jamie Hyneman and Adam Savage contaminated floor tiles with bacteria. Then they dropped crackers and pastrami, picking up the food after two or six seconds. The Mythbusters also had a control in which the food wasn’t dropped at all. They found that all of their samples picked up bacteria, just as in our experiment. Wet pastrami picked up the most. And so Hyneman and Savage declared the myth busted.
Limitations and lessons learned
Our experiment’s results are similar to those of other scientists. We all showed that food has bacteria riding along, whether it’s been dropped for a while, picked up immediately, or never dropped at all.
Of course, no study is perfect. Ours certainly wasn’t. Here are just a few of the problems, or limitations:
- I only dropped my bologna on tile. People drop food on all sorts of surfaces, from carpet to dirt.
- I only tested bologna, instead of several wet and dry foods.
- Like the Mythbusters, I counted bacterial colonies. However, I don’t know which species I was able to grow. And I couldn’t separate bacteria from fungus, which also grew on the plates.
- I tried to create a very clean environment, but the controls show that I didn’t quite succeed.
- I tested clean and dirty floors, but I didn’t know exactly how clean or dirty that floor was. Other scientists solved this by contaminating their floors in a more controlled way.
- I knew exactly what I was testing and what to expect. In other words, I was not blind to the conditions. Because I knew what I was looking for, I could have brought bias into my results.
If I were to do this experiment again, I could try to fix these problems. I could add more flooring types and more food types. I could spread bacteria on my floor beforehand, rather than the contents of my compost pile.
But with other studies showing similar results, all the data declare: This myth is BUSTED! Food has bacteria on it, dropped or not. The bugs will most likely never cause you problems. But microbes certainly aren’t waiting five seconds before colonizing a new bologna world.
Explainr
Follow Eureka! Lab on Twitter